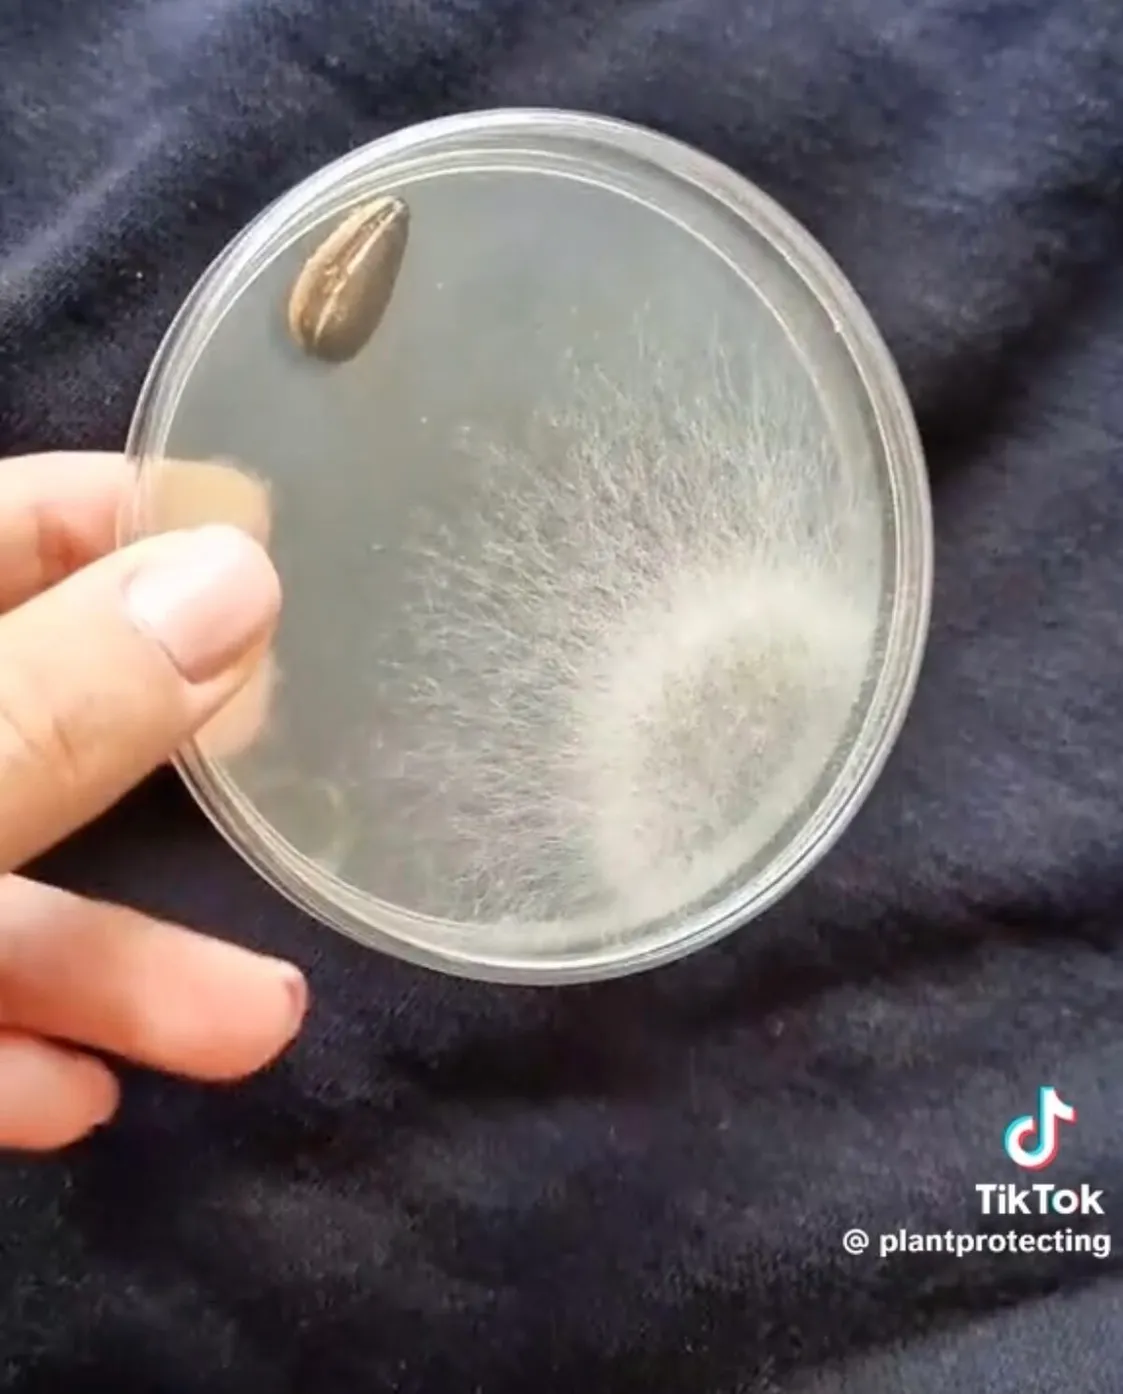

Itt a nagy szotyiteszt: te is a szádba veszed? Mutatjuk, hogy mi van a héján!
Mennyire egészséges a szánkba venni a napraforgómag héját? A nagy szotyiteszt megmutatja.
Gyuris Rita, a TikTok kedvenc növényorvosa rendszeresen mutat be érdekes kísérleteket. Most a napraforgómag héját vette górcső alá. Íme a nagy szotyiteszt.

Szotyiteszt
Rita egy csomag napraforgómagot vásárolt a boltban a kísérletéhez.
„Azt fogom megvizsgálni, hogy a szotyinak a héján van-e valami, ugyanis a szánkba szoktuk venni, amikor megesszük” - mondta a növényorvos.
Egy speciális táptalajra, úgynevezett agar lemezre helyezett néhány szem szotyit, majd jól összerázta azokat, hogy a lemez minden részét érintsék, majd kiborította a magokat. Egy szem a táptalajon ragadt, de azt otthagyta.
Az első napon egy gombatelep nőtt fel a mintán, a kísérlet ötödik napján pedig már teljesen belepte a lemezt a fehér, vattacukorhoz hasonlító gomba.
A növényorvos baktériumot és gombát is talált a napraforgómag héján
A kísérlet végére két baktériumfoltot és egy fajta gombát látott a növényorvos.
„Ettől függetlenül mi még ugyan úgy fogjuk enni”- mondta Rita, aki midig felhívja a figyelmet arra, hogy a baktériumok és gombák az életünk részei és nem kell tőlük kétségbeesni, mindemellett természetesen ügyelni kell a a megfelelő higiéniára.
Rita a bolti zsemlét is letesztelte
"Az első napon egy baktériumkolónia nőtt fel, de a harmadik napra már megjelent a többi baktériumkolónia és gombatelep is" – állapította meg. Rita szerint egyértelmű, hogy a zsömlén található baktériumok az emberek koszos kezéről kerültek a pékárura. A növényorvos megnyugtatta követőit, hogy ezek a mikroorganizmusok nem veszélyesek az emberre nézve.
„A péktermékek egyébként pont az a kategória, amit szeret mindenki jól összefogdosni, hogy a legszebbet tudja kiválasztani. A válogatással egyébként nem lenne probléma, hogyha ezt nem a koszos kezünkkel tennénk, ugyanis nyilvánvaló, hogy ezek a kezünkről kerülnek oda. Ezek a mikroorganizmusok egyébként nem veszélyesek ránk nézve, főleg nem egy egészséges immunrendszernek. Na meg persze ott a gyomorsav.”






